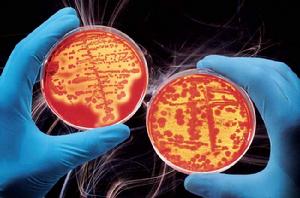
細胞信息記憶素

概述
 環形的線粒體DNA
環形的線粒體DNA細胞信息記憶素,細胞信息記憶素(CIMC),它是線粒體DNA的重要物質,21世紀是一個DNA解碼的時代!線粒體DNA的研究解開了人類衰老的生命密碼,引領著抗衰老的主流,細胞信息記憶素是線粒體DNA中的重要物質,在細胞生長過程中,記錄著與細胞分裂、生長有關的所有信息,形成龐大的信息儲存庫。
主要功能
1、在外界某些物質的刺激下,有可能通過釋放細胞的狀態基因沉澱記憶,喚醒資料庫里的特定信息,恢復細胞在某一時期的皮膚狀態記憶。
2、增強線粒體DNA的活性,提升呼吸鏈利用氧的能力,增強線粒體內脫氫酶的功能。
3、促進ATP酶的大量生成,恢複線粒體活力,為細胞提供必要的能量,以達到修複線粒體,還原飽滿正常細胞,解決皺紋、皮膚鬆弛、暗黃等皮膚問題。
生理機能
細胞信息記憶素
細胞信息記憶素1、皮膚衰老並產生皺紋,這一切的秘密就在於細胞中的核心記憶因子——細胞信息記憶素(CIMC),它是線粒體DNA的重要物質。從20歲開始女人就開始進行眼部的護理,眼周是人生第一條皺紋產生的地方,皺紋一旦出現,就意味著皮膚衰老的通道已經打開,只要通道開關一開啟,就無法停止,所以千萬不要忽視任何一條小小的細紋。
2、細胞信息記憶素存在於細胞的線粒體中,是線粒體DNA的重要物質,具有遺傳性質,對線粒體以及細胞的分裂、生長具有重要的作用。
3、,通過某種特殊物質的刺激,細胞信息記憶素可以通過釋放細胞的狀態基因沉澱記憶,增強線粒體DNA的活性,提升呼吸鏈利用氧的能力,並增強線粒體內脫氫酶的功能,促進ATP酶的大量生成,恢複線粒體活力,為細胞提供必要的能量,進而延緩細胞的死亡和衰老。
衰老原因
 細胞信息記憶素
細胞信息記憶素1、研究表明細胞中95%的能量都是由線粒體通過氧化磷酸化而提供的,而真正決定線粒體數目多少的,卻是線粒體中的細胞信息記憶素。當線粒體數目越多時,細胞的活性就越強,皮膚也就越健康,反之皮膚則會出現衰老現象。
2、細胞供氧不足,就會導致的線粒體損傷,並破壞細胞信息記憶素的調節功能,從而產生線粒體能量代謝障礙、不能合成足夠的ATP以滿足機體代謝的需要,細胞生長所需的營養物質不夠,同時缺氧還會刺激細胞自由基的大量增加,破壞細胞結締組織,最終造成細胞的衰亡。
3、科學研究表明,由缺氧所致的細胞凋亡,首先表現為線粒體功能紊亂,尤其是線粒體跨膜電位(△ψm)的破壞。當組織細胞嚴重缺氧時,ATP生成減少,使鈉泵功能障礙,細胞內Na+增多,促進細胞內鈉水瀦留,導致線粒體膜通透性增加,以及線粒體腫脹。當線粒體的氧分壓(PO2)下降到臨界點1mmHg時,可抑制了線粒體內脫氫酶的功能,ATP生成進一步減少,呼吸鏈被破壞,造成細胞的死亡,皮膚就會出現皺紋、衰老現象。
4、細胞在缺氧的情況下,繼續消耗氧為細胞製造能量時,刺激了副產品——自由基的大量生成,並導致細胞內自由基數量的失衡。大量的自由基不僅會侵害線粒體內膜,導致線粒體能量產生的下降,同時也會攻擊線粒體DNA,使線粒體受損並無法得到修復,最終導致細胞因能量下降而趨向衰亡,加速肌膚的老化進程。
